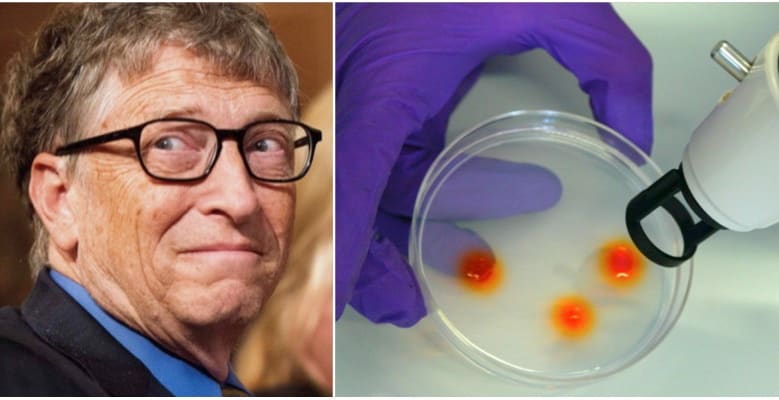

Bill Gates-backad startup samlade in 800 miljoner
Bioteknik-företaget Editas Medicine fick in över 800 miljoner kronor när de som första företag för året introducerats på USA:s Nasdaq-börs. Företaget, som arbetar med att utveckla teknik för att ersätta felaktiga och skadliga gener med friska sådana, samlade så sent som i augusti in över en miljard kronor till forskningsändamål. Bland investerarna finns Microsoftgrundaren och filantropen Bill Gates.
bakgrund
CRISPR
Wikipedia (en)
Clustered regularly-interspaced short palindromic repeats (abbreviated as CRISPR, pronounced crisper) are segments of prokaryotic DNA containing short repetitions of base sequences. Each repetition is followed by short segments of "spacer DNA" from previous exposures to a bacterial virus or plasmid.
The CRISPR/Cas system is a prokaryotic immune system that confers resistance to foreign genetic elements such as plasmids and phages, and provides a form of acquired immunity. CRISPR spacers recognize and cut these exogenous genetic elements in a manner analogous to RNA interference in eukaryotic organisms. CRISPRs are found in approximately 40% of sequenced bacteria genomes and 90% of sequenced archaea.
The CRISPR interference technique has enormous potential application, including altering the germline of humans, animals and other organisms, and modifying the genes of food crops. By delivering the Cas9 protein and appropriate guide RNAs into a cell, the organism's genome can be cut at any desired location. CRISPRs have been used in concert with specific endonuclease enzymes for genome editing and gene regulation in species throughout the tree of life. Ethical concerns have been expressed about this nascent biotechnology and the prospect of editing the human germline.
Omni är politiskt obundna och oberoende. Vi strävar efter att ge fler perspektiv på nyheterna. Har du frågor eller synpunkter kring vår rapportering? Kontakta redaktionen